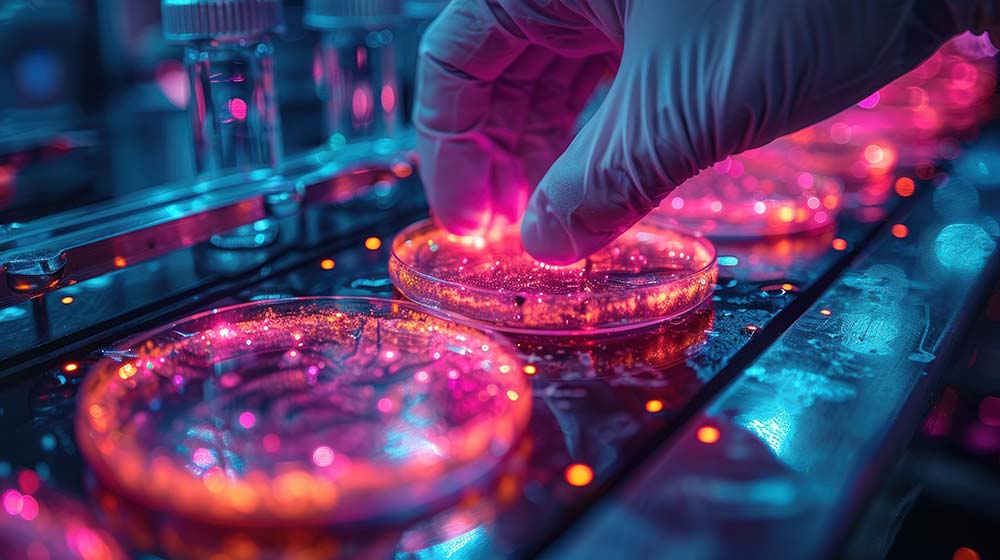

探讨与争鸣
当AI开始设计化妆品:
科学革命还是营销幻影?
2025年12月03日 08:20
在科技浪潮席卷各行各业的今天,你的梳妆台也未能幸免。当各大美妆品牌纷纷打出“AI定制”、“算法配方”的旗号时,我们不禁要问:这究竟是引领护肤未来的科学革命,还是精心包装的营销噱头?要拨开迷雾,看清本质,我们需要深入了解AI是如何“涉足”化妆品领域的,以及它目前的能与不能。
想象一下,传统的化妆品研发如同一位经验丰富的厨师,依靠多年的经验和反复试错来创造新菜谱。而AI,则像是一个拥有过目不忘本领、并阅读了全球所有菜谱和食客评价的超级美食家。它在化妆品研发中扮演的角色,主要体现在以下几个层面:
1、海量数据分析与预测:AI能够以人类无法企及的速度和处理能力,分析数以万计的化学成分、皮肤生理学数据、文献研究、消费者反馈乃至气候环境信息。通过深度学习,它可以找出成分之间隐藏的关联性,预测哪种成分组合对特定皮肤问题(如保湿、抗皱、美白)最有效,从而大幅缩短研发周期,从数年可能缩短至数月。
2、精准优化与效率提升:在确定基础配方后,AI可以模拟成分之间的相互作用,预测配方的稳定性、肤感、渗透性等。研发人员无需进行无数次繁琐的物理实验,只需在计算机模型中调整参数,AI就能快速给出最优解,这极大地节约了时间和成本。
3、个性化定制的未来蓝图:这是AI最令人憧憬的潜力所在。理论上,结合你的基因数据、皮肤屏障状况、微生物组信息和生活习惯,AI可以为你量身打造独一无二的精华或面霜。这意味着,护肤将从一个“通用方案”时代,迈入真正意义上的“一人一方”的精准时代。
尽管前景诱人,但我们必须清醒地认识到,AI在化妆品领域的应用仍处于“青春期”,远未成熟。
1、数据质量决定AI高度:“垃圾进,垃圾出”是计算机领域的铁律。如果用于训练AI的数据本身不全面、有偏差或质量不高,那么AI得出的结论也可能是片面甚至错误的。高质量的生物学数据和明确的功效关联,仍然是行业的核心壁垒。
2、“黑箱”难题:AI的决策过程有时像一个黑箱子,我们能知道它给出的结果,却很难完全理解它为何会得出这个结论。这在讲究作用机理和安全性验证的化妆品科学中,是一个需要持续攻克的挑战。
3、概念的过度包装:这正是当前市场乱象的根源。有些品牌可能仅仅是用AI分析了消费者偏好,设计了一下包装,或者做了一个简单的肤质测试问卷,就冠以“AI定制”的名头,其核心配方与传统产品并无本质区别。这里的AI,更多地扮演了营销工具,而非研发核心。
那么,作为消费者,我们如何辨别真伪,避免被“收割智商税”呢?关键在于抓住一个核心:扎实的科学验证。
1、看穿话术:警惕那些空有“AI”名头,却讲不清具体技术路径和科学依据的品牌。真正的AI研发,品牌通常会乐于分享其合作的技术平台、数据分析维度以及初步的研究成果。
2、追问证据:无论配方由谁设计,最终都必须回归到化妆品监管的基本要求上来。产品是否通过了严格的人体功效评测(如第三方权威机构的临床测试)?是否公布了详实的实验数据?成分和宣称的功效是否有公开发表的文献支持?
3、理性看待“定制”:目前阶段,绝大多数“AI定制”仍停留在有限的选项组合(如选择肤质、核心诉求),而非从分子层面为你创造全新成分。对此抱有合理的预期,能帮助你做出更明智的选择。
AI设计化妆品,无疑是一场正在发生的、深刻的科学演进。它在提升研发效率、探索未知成分组合方面展现出巨大潜力,代表了行业未来的发展方向。
然而,在技术完全成熟之前,它也被一部分玩家用作华丽的营销外衣。我们不必因噱头而全盘否定技术的价值,也不应因对科技的崇拜而放弃批判性思考。
最终衡量一款产品好坏的,不是它由“人”还是由“AI”设计,而是它是否具备坚实的科学基础、透明的验证过程和实实在在的使用效果。作为消费者,练就一双火眼金睛,在科技的炫光中牢牢抓住“科学验证”这根准绳,我们才能真正享受到技术进步带来的美与好。
Bioπ中国美肤科学传播平台发布本文只是为了更多的信息参考,不代表任何有倾向性的投资意见或市场暗示。
THE END
指导单位:中国香料香精化妆品工业协会
受托运营:中国香妆融媒体
京ICP备2025131973号